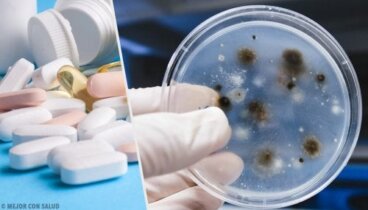
Traitement de la blastomycose

Alejandro Duarte
Diplômé en biotechnologie. Alejandro Duarte possède des connaissances approfondies en biologie cellulaire et moléculaire, il a également appartenu à différentes équipes de recherche et a été éditeur SEO d'articles à thème scientifique, spécialisé en médecine et santé.
A propos de l'auteur
Diplômé en biotechnologie au sein de l'Université de León (2017). Il étudie une maîtrise en recherche et marketing des médicaments au sein de la Fondation Teófilo Hernando en collaboration avec l'Université autonome de Madrid .
Pendant 17 mois, il a été impliqué dans différentes équipes de recherche au sein de la Faculté des Sciences Biologiques de l'Université de León. De plus, il a travaillé dans plusieurs laboratoires d'analyses cliniques, et a travaillé en tant que réviseur de contenus axés sur la santé et le bien-être.
Il travaille actuellement chez IQVIA, une organisation multinationale dédiée à la conduite d'essais cliniques.
Il a un intérêt marqué pour la biomédecine moléculaire qui l'a amené à poursuivre une carrière en recherche clinique.